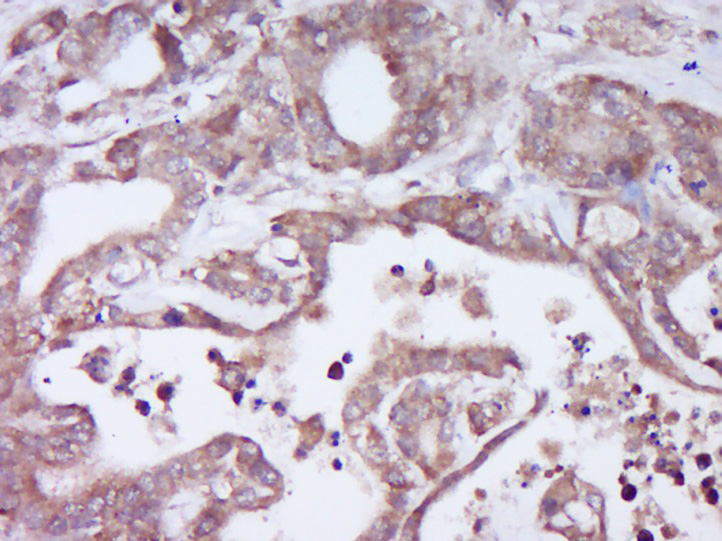
产品细节图片1

相关产品推荐更多 >

Histone H4 (Acetyl K16) Rabbit pAb, Cy5.5 conjugated(bs-4707R-Cy5.5)-100ul
¥2980
ADRB2 Rabbit pAb(bs-0947R)-50ul/100ul/200ul
¥1180
CXCR4 Rabbit pAb, BF750 conjugated(bs-20318R-BF750)-100ul
¥2980
Smad1 Rabbit pAb, BF647 conjugated(bs-1619R-BF647)-100ul
¥2980
NeuN Recombinant Rabbit mAb(bsm-52268R)-50ul/100ul/25ul
¥800
万千商家帮你免费找货
0 人在求购买到急需产品
- 详细信息
- 文献和实验
- 技术资料
- 应用范围:
产品信息以Bioss网站为准
- 规格:
50ul/100ul/200ul
| 规格: | 50ul | 产品价格: | ¥1180.0 |
|---|---|---|---|
| 规格: | 100ul | 产品价格: | ¥1980.0 |
| 规格: | 200ul | 产品价格: | ¥2800.0 |
| 产品编号 | bs-14243R |
| 英文名称 | DEFB109 Rabbit pAb |
| 中文名称 | 防御素β-109/β-defensin 109抗体 |
| 英文别名 | beta defensin 109; DB109_HUMAN; DEFB109 beta defensin 109; Defensin beta 109. |
| 产品应用 | IHC-P=1:100-500, IHC-F=1:100-500, IF=1:100-500 Not yet tested in other applications. |
| 交叉反应 | Human |
| 抗体来源 | Rabbit |
| 免疫原 | KLH conjugated synthetic peptide derived from human DEFB109 |
| 亚型 | IgG |
| 性状 | Liquid |
| 纯化方法 | affinity purified by Protein A |
| 克隆类型 | Polyclonal |
| 理论分子量 | 7.4 kDa |
| 浓度 | 1mg/ml |
| 储存液 | 0.01M TBS (pH7.4) with 1% BSA, 0.02% Proclin300 and 50% Glycerol. |
| 亚细胞定位 | Secreted |
| 相似性 | Belongs to the beta-defensin family. |
| 功能 | DEFB109 belongs to the beta defensin family. It has antibacterial activity. |
| 保存条件 | Shipped at 4℃. Store at -20℃ for one year. Avoid repeated freeze/thaw cycles. |
| 注意事项 | This product as supplied is intended for research use only, not for use in human, therapeutic or diagnostic applications. |
| 背景资料 | Beta-defensins are small cationic peptides with broad-spectrum antimicrobial activity against a variety of enveloped viruses, fungi and bacteria. Produced in mucosal epithelia and neutrophils of several species, Beta-defensins are developmentally regulated. The family of Beta-defensin proteins share a common defensin-motif that is characterized by multiple cysteine residues and a highly conserved tertiary structure. Besides playing a significant role in host immune defense, many Beta-defensins also are involved in sperm maturation and capacitation. Beta-defensin 109 is an 87 amino acid secreted protein that is notably expressed on the ocular surface and is found in reduced levels in microbial infection, therefore suggesting that this particular Beta-defensin is unlikely to have a major antimicrobial effect. |
| 应用 | 推荐稀释比例 |
| {IHC-P} | {1:100-500} |
| {IHC-F} | {1:100-500} |
| {IF} | {1:100-500} |
风险提示:丁香通仅作为第三方平台,为商家信息发布提供平台空间。用户咨询产品时请注意保护个人信息及财产安全,合理判断,谨慎选购商品,商家和用户对交易行为负责。对于医疗器械类产品,请先查证核实企业经营资质和医疗器械产品注册证情况。
文献和实验= NAL), appears to form upon oxidative cyclization of the nonfluorescent 2:1 lysine-HNE Michael adduct-Schiff base cross-link (Scheme 1). Polyclonal antibody (PAb) to the NAL-HNE fluorophore was raised in rabbit and found to be highly specific
GE Healthcare Benzamidine Sepharose™ 6B is p-aminobenzamidine covalently attached to Sepharose 6B by the epoxy coupling method. p-Aminobenzamidine (PAB), is a synthetic inhibitor of trypsin-like serine protease. Trypsin and trypsin
Nucleic Acid Programmable Protein Arrays: Versatile Tools for Array‐Based Functional Protein Studies
.g., Sigma) 50 mg/ml bis‐sulfosuccinimdylsuberate (BS3 ;Pierce, cat. no. PI 21580) in dimethylsulfoxide (DMSO) 5 mg/ml
技术资料暂无技术资料 索取技术资料






